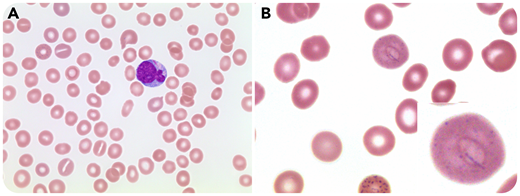
An 8-year-old girl presented with a 4-week history of bruising in her legs and arms. She had weight loss without fevers or night sweats. On initial workup, her bloodwork showed leukocytes 25 × 109/L, hemoglobin 80 g/L, and platelets 11 × 109/L. Her blood film revealed myeloblasts 16.8 × 109/L with several containing Auer rods (panel A; original magnification ×500; Wright-Giemsa stain) and red blood cells with basophilic stippling and a Cabot ring (panel B; original magnification ×1000; Wright-Giemsa stain). Subsequent bone marrow aspirate and biopsy confirmed an underlying diagnosis of acute myelomonocytic leukemia, but other cell lines did not demonstrate any dysplastic changes. Cytogenetics did not reveal any abnormalities (normal female karyotype). Molecular studies showed biallelic CEBPA mutation. The patient achieved complete remission after induction chemotherapy, and no remaining blasts or Cabot ring were appreciated on subsequent peripheral blood films.

An 8-year-old girl presented with a 4-week history of bruising in her legs and arms. She had weight loss without fevers or night sweats. On initial workup, her bloodwork showed leukocytes 25 × 109/L, hemoglobin 80 g/L, and platelets 11 × 109/L. Her blood film revealed myeloblasts 16.8 × 109/L with several containing Auer rods (panel A; original magnification ×500; Wright-Giemsa stain) and red blood cells with basophilic stippling and a Cabot ring (panel B; original magnification ×1000; Wright-Giemsa stain). Subsequent bone marrow aspirate and biopsy confirmed an underlying diagnosis of acute myelomonocytic leukemia, but other cell lines did not demonstrate any dysplastic changes. Cytogenetics did not reveal any abnormalities (normal female karyotype). Molecular studies showed biallelic CEBPA mutation. The patient achieved complete remission after induction chemotherapy, and no remaining blasts or Cabot ring were appreciated on subsequent peripheral blood films.
Current understanding suggests that these rings represent microtubules from the mitotic spindle that remain behind after the rest of the erythrocyte nucleus is extruded. The literature reports that based on the basophilic staining, it is postulated that this is seen in diseases with stressed bone marrow, including acute leukemia, lead poisoning, and sideroblastic anemia, as well as a few other clinical scenarios.
An 8-year-old girl presented with a 4-week history of bruising in her legs and arms. She had weight loss without fevers or night sweats. On initial workup, her bloodwork showed leukocytes 25 × 109/L, hemoglobin 80 g/L, and platelets 11 × 109/L. Her blood film revealed myeloblasts 16.8 × 109/L with several containing Auer rods (panel A; original magnification ×500; Wright-Giemsa stain) and red blood cells with basophilic stippling and a Cabot ring (panel B; original magnification ×1000; Wright-Giemsa stain). Subsequent bone marrow aspirate and biopsy confirmed an underlying diagnosis of acute myelomonocytic leukemia, but other cell lines did not demonstrate any dysplastic changes. Cytogenetics did not reveal any abnormalities (normal female karyotype). Molecular studies showed biallelic CEBPA mutation. The patient achieved complete remission after induction chemotherapy, and no remaining blasts or Cabot ring were appreciated on subsequent peripheral blood films.
Current understanding suggests that these rings represent microtubules from the mitotic spindle that remain behind after the rest of the erythrocyte nucleus is extruded. The literature reports that based on the basophilic staining, it is postulated that this is seen in diseases with stressed bone marrow, including acute leukemia, lead poisoning, and sideroblastic anemia, as well as a few other clinical scenarios.
For additional images, visit the ASH Image Bank, a reference and teaching tool that is continually updated with new atlas and case study images. For more information, visit http://imagebank.hematology.org.

This feature is available to Subscribers Only
Sign In or Create an Account Close Modal